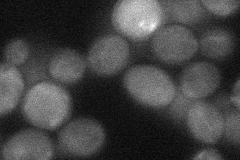
YLR352W
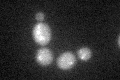
YLR352W

View description
Putative protein of unknown function with similarity to F-box proteins; interacts with Skp1p and Cdc53p; YLR352W is not an essential gene
Localization:
Intensity:
Fold change:
Significance:
-
C’ GFP library in SD

nucleolus48.96 -
N' NOP1pr-GFP in SD

cytosol41.7909 -
N' TEF2pr-mCherry in SD

cytosol40.8578 -
N' NATIVEpr-GFP in SD

below threshold20.643 -
N' TEF2pr-VC and Cyto-VN in SD
cytosol37.4057 -
C’ GFP library in SD+DTT
nucleolus30.310.61Yes -
C’ GFP library in SD+H2O2

nucleolus32.30.65No -
C’ GFP library in Starvation Media

nucleolus17.950.36Yes -
C’ GFP library on the background of Pup2-DaMP

nucleolus -
C’ GFP library on the background of CCT mutant

nucleolus37.18170.759302No
